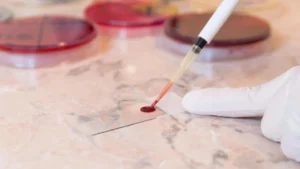
Të fundit

NASA dhe Lockheed Martin testojnë me sukses aeroplanin supersonik X-59
NASA dhe Lockheed Martin kanë testuar me sukses X-59, një aeroplan reaktiv supersonik i projektuar për të fluturuar më shpejt se zëri me zhurmë minimale – një hap drejt ringjalljes së udhëtimeve komerciale të qeta dhe me shpejtësi të lartë.
Aeroplani supersonik X-59 i NASA-s realizoi fluturimin e tij të parë mbi shkretëtirën e Kalifornisë këtë javë, duke shënuar një moment të rëndësishëm në përpjekjet për të rikthyer udhëtimin ajror me shpejtësi të lartë.
I ndërtuar nga NASA dhe Lockheed Martin, aeroplani është projektuar të fluturojë më shpejt se zëri, duke prodhuar vetëm një “bum” të butë në vend të një bumi zanor.
Fluturimi provë u përqendrua në integritetin strukturor dhe aeroplani u ul në mënyrë të sigurt në Qendrën Kërkimore të Fluturimeve Armstrong të NASA-s.
Ky test afron ëndrrën e udhëtimit supersonik të pasagjerëve më afër realitetit. Nëse teknologjia do të ketë sukses, ajo mund të shkurtojë kohën e fluturimeve midis qyteteve si New Yorku dhe Los Angeles pothuajse përgjysmë, duke ringjallur ëndrrën e dikurshme të Concorde për një epokë të re të udhëtimit komercial me shpejtësi të lartë.